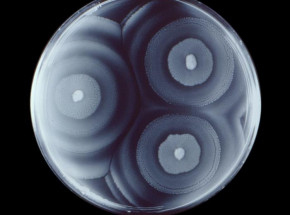
Opracowano nową metodę szyfrowania wiadomości opartą na wzorcach wzrostu bakterii

Nicki Minaj, Bukayo Saka i inne gwiazdy w nowym zwiastunie „Call of Duty: Modern Warfare 2”
W materiale wystąpili również inni celebryci z USA.
W materiale wystąpili również inni celebryci z USA.
Uruchomienie sprzedaży zaliczy małe opóźnienie.
Tytuł nie został ciepło przyjęty.
Kolejny sposób na poznanie świata Night City.
Nowa wersja gry ma zostać udostępniona w sieci.
Platforma działała od ponad dziesięciu lat.
Riot Games przywraca elementy rozgrywki z początku...
W nowego NFSa zagramy jeszcze w tym roku.
Poznaliśmy plany studia na najbliższe lata.
Grę przejdziemy w mniej niż 24 godziny.
Nagroda przyznana została Alainowi Aspectowi, Johnowi...
Premiera 2 grudnia.
Zwycięzcą został szwedzki biolog Svante Pääbo za...
Już wkrótce wyprzedaż z okazji Halloween.
Bakterie rozwijają się w zależności od określonych...
Sequel uwielbianej przez społeczność gry zbliża...
W sieci zawitał zwiastun ujawniający możliwości...
O wynikach badań poinformował Instytut Genetyki...
Premiera już tej jesieni.
To dodatek Bloody Ties.
Za realizację odpowiada Motive Studio.
Informację potwierdziło studio Nixxes Software.
Premiera w październiku tego roku.
Materiały ujrzały światło dzienne w niedzielny...
Głos w sprawie zabrał Jason Schreier.
Na YouTube zaprezentowano zwiastun.
Do wygrania między innymi kontroler do gier.
Gepard został uznany w Indiach za gatunek wymarły w...
Premiera już 9 listopada.
Premiera już 19 października.
Wideo zawiera ekskluzywną misję dla Ps4.
Dodatki naturalnie wciąż będą płatne.
W tytuł zagramy jeszcze w tym roku.
Data premiery nie jest znana.
Projekt będzie większą produkcją RPG.
Gra będzie prequelem „Valhalli”.
Twórcy nie przewidują dalszych opóźnień.
Informację podali sami deweloperzy.
Projekt zaprezentowano na tegorocznym D23.
Informacja wyciekła w sklepie Epic Games Store.
Data premiery wciąż nie jest znana.
Gra zadebiutowała wczoraj.
Tytuł jest darmowy.
Premiera jeszcze w tym roku.
To dodatek „Phantom Liberty”.
Decyzja o pierwszym miejscu podzieliła internautów.
Nowy gameplay oszałamia warstwą wizualną.